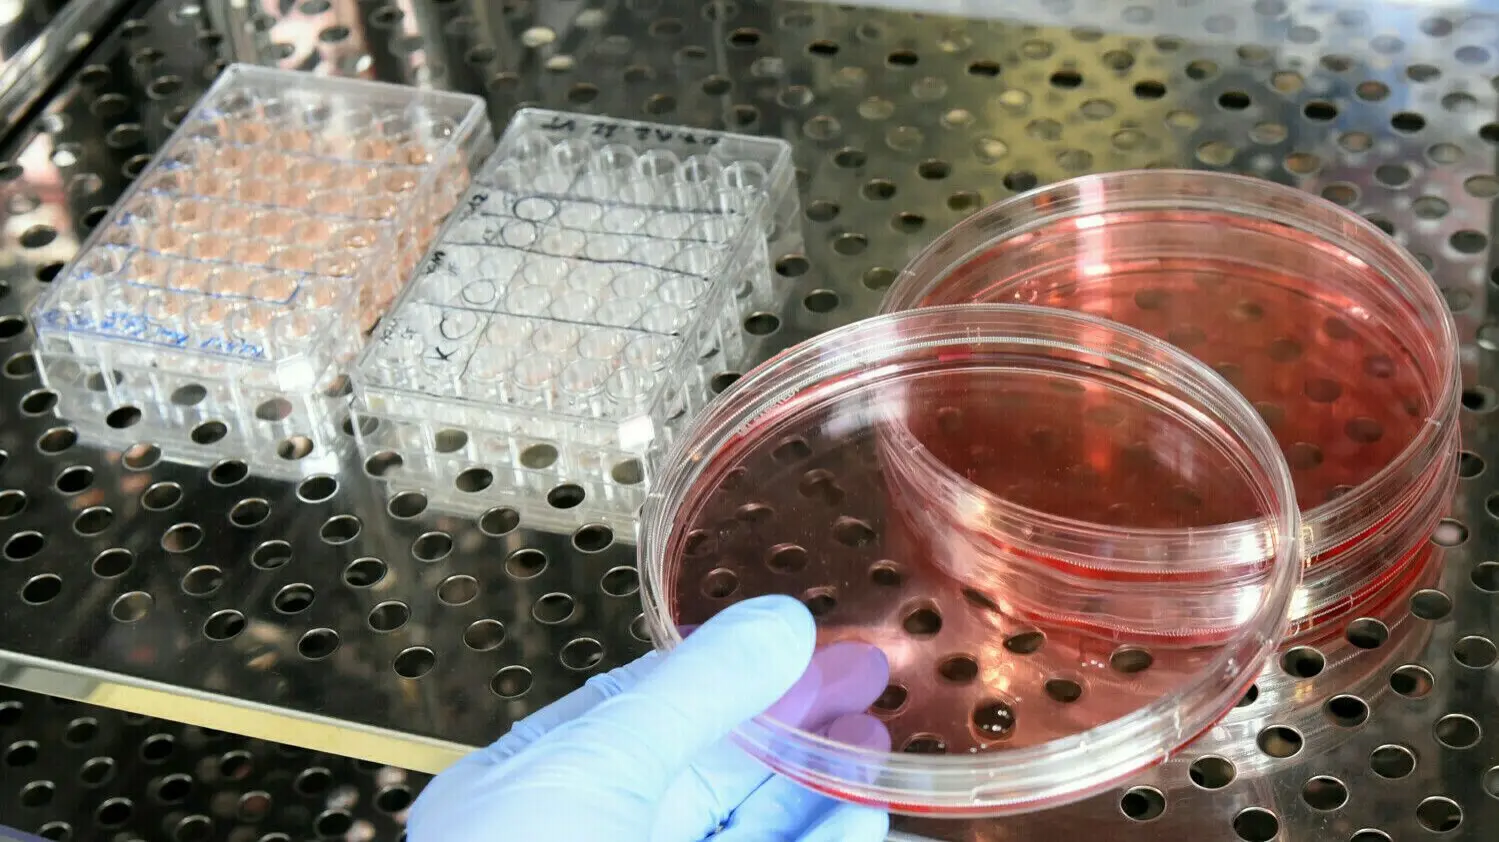

'/%3e%3cpath%20fill='%2300a2ca'%20fill-rule='nonzero'%20d='M55.9851361%206.04040555h-5.7611779c-4.4117128%200-8.04488805%203.63317525-8.04488805%208.04488806%200%204.4117128%203.63317525%208.04488805%208.04488805%208.04488805%204.4117128%200%208.04488806-3.63317525%208.04488806-8.04488805V8.3241157c0-1.24566009-1.03805008-2.28371016-2.28371016-2.28371016Zm-2.64702768%209.03103562h-2.12800265v2.12800265c0%20.51902504-.46712253.93424506-.98614757.93424506s-.98614757-.41522002-.98614757-.93424506v-2.12800265H47.109808c-.51902504%200-.93424507-.46712253-.93424507-.98614756%200-.51902504.41522003-.98614757.93424507-.98614757h2.12800264v-2.12800265c0-.51902504.46712253-.93424506.98614757-.93424506s.98614757.41522002.98614757.93424506v2.12800265h2.12800265c.51902503%200%20.93424506.46712253.93424506.98614757%200%20.51902503-.41522003.98614756-.93424506.98614756Z'/%3e%3cpath%20fill-rule='nonzero'%20d='m12.4389356%208.99884825%202.28371015%207.0587405%202.28371016-7.0587405h3.21795522v10.1728907h-2.43941767V16.7842238l.25951252-4.87883534-2.43941767%207.2663505H13.9441082l-2.49132018-7.2663505.25951252%204.87883534v2.38751517H9.22098037V8.99884826h3.21795522Zm17.90636373%205.29405537c0%20.98614757-.15570751%201.86849013-.57092754%202.64702768-.36331753.77853756-.88234256%201.3494651-1.5570751%201.76468512-.67473256.41522003-1.4532701.62283005-2.33561267.62283005-.88234256%200-1.60897761-.20761002-2.28371016-.62283005-.67473254-.41522002-1.19375758-.98614756-1.5570751-1.71278261-.36331753-.72663505-.57092754-1.60897762-.62283005-2.54322268v-.57092754c0-.98614757.15570751-1.86849013.57092754-2.64702768.41522003-.77853756.88234256-1.3494651%201.5570751-1.76468512.67473256-.41522003%201.4532701-.62283005%202.33561267-.62283005.83044006%200%201.60897761.20761002%202.28371016.62283005.67473254.41522002%201.19375758.98614756%201.5570751%201.76468512.36331753.72663505.57092754%201.6089776.57092754%202.59512518l.0519025.46712253Zm-2.49132017-.41522003c0-.98614757-.15570751-1.76468512-.51902504-2.28371016-.36331753-.51902503-.83044006-.77853755-1.4532701-.77853755-1.24566009%200-1.86849013.93424506-1.97229514%202.75083269v.72663505c0%20.98614757.15570751%201.76468512.51902504%202.28371016.31141502.51902503.83044006.77853755%201.4532701.77853755.62283004%200%201.08995257-.25951252%201.4013676-.77853755.31141502-.51902504.51902503-1.2975626.51902503-2.28371016v-.41522003h.0519025Zm6.38400794%203.37366273h4.87883533v1.86849013h-7.99298555v-1.29756259l4.82693284-7.00683798h-4.87883534V8.99884825h7.88918054v1.24566009l-4.72312782%207.00683798Z'/%3e%3c/svg%3e)
Einkaufen in Frankfurt (Oder): Kolibakterien und Salmonellen – was Tests im Einzelhandel ergeben
Lebensmittelkontrolleure haben für das jüngste Zoonosen-Monitoring bundesweit Betriebe unter die Lupe genommen. Auch in Frankfurt (Oder) nahmen die Tester mehrere Proben. Diese fielen nicht immer appetitlich aus.
Lebensmittelkontrolleure haben im Auftrag von Verbraucherschützern bundesweit Proben genommen. Wie sind sie in Frankfurt (Oder) ausgefallen? (Symbolfoto)
Waltraud Grubitzsch/dpa